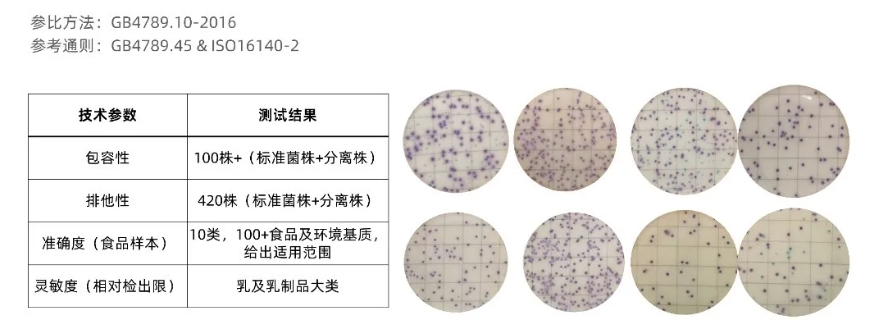
bidui1.png

Premium系列金黄色葡萄球菌测试片经过充分方法验证
2024-09-12 11:40浏览量:230
近几年, 随着国际交流合作的开展、标准的进步以及我国科研水平的提高, 相继出现了许多快速检测及鉴定技术和产品, 食品微生物检测及鉴定技术也取得了较大的进展,通过缩短检测时间、提高检测效率等方式进一步提高食品中微生物的检测准确性和效率。
乳制品、婴幼儿食品、特殊医学用途配方食品、饮料、冷链食品等生产许可审查细则几乎都提到“可以使用快速检验方法/非标方法进行出厂检验”。
规范中要求:使用快速检测方法的,应定期与国家标准规定的检验方法进行比对或验证,保证检测结果准确。当快速检测方法检测结果显示异常时,应使用国家标准规定的检验方法进行验证。
所以,充分的方法验证是“合规使用微生物快速检验方法出厂检验”重要依据。
Premium系列金黄色葡萄球菌测试片充分方法验证
在国内,我们这样做~~
以GB4789.10-2016第一法、第二法为参比标准,参考ISO16140-2: 2016中性能指标对测试片进行验证。
定量验证包含:包容性、排他性、一致性、相对正确度、准确度。
定性验证包含:包容性、排他性、灵敏度和相对检出限。
实验室内部验证
第三方实验室验证(SGS)

实验结果
实验结果表明各参数指标均符合ISO16140-2: 2016和GB4789.45中对于验证指标的要求。部分验证报告截图如下:
在国际上,开展AOAC-PTM认证
此前,LR1005金黄色葡萄球菌测试片已经获得AOAC-PTM认证,针对Premium系列金黄色葡萄球菌测试片,我们已经在申请AOAC-PTM认证过程中。

上一篇: 美正助力毒枸杞筛查,让硫超标无处可逃!


 鲁公网安备37110202000421号
鲁公网安备37110202000421号